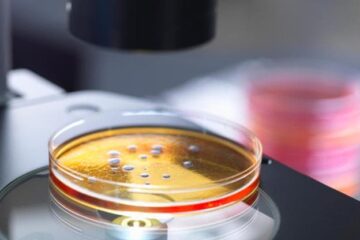

News
Diritti dell’infanzia: all’aria aperta o in gruppo, ecco perché giocare fa bene alla salute dei bambini
Rincorrersi, saltare, costruire capanne, inventare storie con gli amici: giocare è qualcosa che i bambini fanno ogni giorno, in modo spontaneo. Ma al di là del divertimento, giocare è davvero…
News
Super batteri uccidono più di influenza, Aids e Tbc insieme. Ecco le terapie allo studio per fermarli
Qualcuno l’ha già ribattezzata la nuova pandemia silenziosa: quella dei super batteri resistenti agli antibiotici e antimicrobici. Una emergenza che ogni anno nell’Unione europea provoca oltre 35mila morti per infezioni,…
News
Mammografie e Tac, così l’IA aiuta il medico a individuare ciò che è sospetto
In Italia, ogni anno, vengono eseguite più di 70 milioni di prestazioni diagnostiche per immagini per un business in costante crescita che a livello globale punta a raggiungere quota 60…
News
Così riscaldamento globale e inquinamento indeboliscono spermatozoi e fertilità maschile
L’Italia è uno dei Paesi con il tasso di natalità più bassi al mondo. Un dato allarmante che trova radici in molteplici fattori socioeconomici e culturali, ma anche in cause…